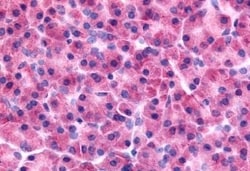
Invitrogen PAK7 Polyclonal Antibody 50 &mu;g; Unconjugated:Antibodies,

missing translation for 'onlineSavingsMsg'
Learn More
Learn More
Invitrogen™ PAK7 Polyclonal Antibody


Rabbit Polyclonal Antibody
Brand: Invitrogen™ PA534102
This item is not returnable.
View return policy
Description
Percent identity with other species by BLAST analysis: Human, Gorilla (100%) Orangutan, Gibbon, Monkey (95%) Marmoset (90%).
PAK7 (KIAA1264) is implicated in the regulation of cytoskeletal dynamics, proliferation, and cell survival signaling. This kinase contains a CDC42/Rac1 interactive binding motif, and has been shown to bind CDC42 in the presence of GTP. This kinase is predominantly expressed in brain. It is capable of promoting neurite outgrowth, and thus may play a role in neurite development. This kinase is associated with microtubule networks and induces microtubule stabilization. The subcellular localization of this kinase is tightly regulated during cell cycle progression. Alternatively spliced transcript variants encoding the same protein have been described.
Specifications
| PAK7 | |
| Polyclonal | |
| Unconjugated | |
| PAK5 | |
| 2900083L08Rik; 6430627N20; KIAA1264; p21 (CDKN1A)-activated kinase 7; p21 (RAC1) activated kinase 5; p21 (RAC1) activated kinase 7; p21 protein (Cdc42/Rac)-activated kinase 7; p21(CDKN1A)-activated kinase 7; p21-activated kinase 5; p21-activated kinase 7; p21CDKN1A-activated kinase 7; PAK 5; PAK 7; PAK5; PAK-5; Pak7; PAK-7; protein kinase PAK5; RP5-1119D9.3; Serine/threonine-protein kinase PAK 5; serine/threonine-protein kinase PAK 7; serine/threonine-protein kinase PAK7 | |
| Rabbit | |
| Antigen affinity chromatography | |
| RUO | |
| 57144 | |
| Store at 4°C short term. For long term storage, store at -20°C, avoiding freeze/thaw cycles. | |
| Liquid |
| Immunohistochemistry (Paraffin) | |
| 1 mg/mL | |
| PBS with 0.1% sodium azide | |
| Q9P286 | |
| PAK5 | |
| Synthetic 20 amino acid peptide from internal region of human PAK7. | |
| 50 μg | |
| Primary | |
| Human | |
| Antibody | |
| IgG |
Product Content Correction
Your input is important to us. Please complete this form to provide feedback related to the content on this product.
Product Title
Spot an opportunity for improvement?Share a Content Correction